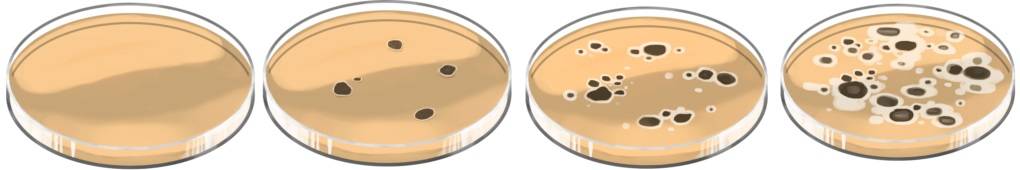

Tier- und Pflanzenzellen (Eukaryoten)
Einfach lernen mit Videos, Übungen, Aufgaben & Arbeitsblättern
Jetzt mit Spaß die Noten verbessern
und sofort Zugriff auf alle Inhalte erhalten!
30 Tage kostenlos testenInhaltsverzeichnis zum Thema
- Aufbau und Funktion von Zellen
- Gemeinsamkeiten von Pflanzen- und Tierzellen
- Besonderheiten von Pflanzenzellen
- Energiegewinnung von Zellen: Autotrophie und Heterotrophie
- Zelldifferenzierung
- Eukaryoten und Prokaryoten
Aufbau und Funktion von Zellen
Zellen sind die Bausteine, aus denen Menschen, Pflanzen und Tiere aufgebaut sind. Sie sind die kleinsten Einheiten des Lebens, die sich selbstständig teilen und am Leben erhalten können. Im Jahre 1665 entdeckte Robert Hooke mithilfe der ersten Mikroskope erstmals Zellen in Kork, später dann in Pflanzenzellen. 1839 konnte der Wissenschaftler Theodor Schwann zeigen, dass Pflanzen und Tiere aus Zellen bestehen.
Gemeinsamkeiten von Pflanzen- und Tierzellen
Von wenigen Ausnahmen abgesehen, haben alle Zellen – ganz egal, ob bei Mensch, Pflanze oder Tier – viele Bestandteile gemeinsam. Der Aufbau der Tierzelle ähnelt also dem Aufbau der Pflanzenzelle. Sie enthalten die genetische Information – die DNA (Desoxyribonukleinsäure) – , die als Bauplan für alle Bauteile und Funktionen der Zelle dient und für die spätere Zellteilung wichtig ist.
Zudem verfügen sie über eine Vielzahl unterschiedlicher Eiweiße (Proteine), die die Zelle aufbauen oder für den Stoffwechsel wichtig sind. Sogenannte Zellmembranen umhüllen das Innere der Zelle und grenzen es gegenüber der Umgebung oder anderen Zellen ab. Dadurch entstehen geschlossene Reaktionsräume, sogenannte Kompartimente . Zusätzlich fungieren die Zellmembranen auch als Filter und erhalten den Kontakt zur Außenwelt aufrecht.

Besonderheiten von Pflanzenzellen
Im Unterschied zu den Zellen von Menschen und Tieren haben Pflanzenzellen noch eine zusätzliche Zellwand als äußere Grenze. Und sie verfügen über Chloroplasten, die für die spezielle Form der Energiegewinnung von Pflanzen – die Fotosynthese – wichtig ist. Mit ihrer Hilfe gewinnen Pflanzen aus Kohlenstoffdioxid und dem Licht der Sonne Energie. Ganz nebenbei produzieren sie dabei Sauerstoff, der für fast alle anderen Lebewesen auf der Erde lebensnotwendig ist. Die grüne Färbung kommt übrigens vom sogenannten Blattgrün oder Chlorophyll.
Energiegewinnung von Zellen: Autotrophie und Heterotrophie
Um zu überleben und sich zu vermehren sind wir auf die Energiegewinnung der Zellen angewiesen. Die Fotosynthese ist eine Form der Energiegewinnung, die als Autotrophie bezeichnet wird. Sie bedeutet übersetzt „Selbsternährung“. Autotrophe Lebewesen können Energie und organische Baustoffe aus anorganischen Verbindungen (z.B. Kohlenstoffdioxid) aufbauen.
Der Gegensatz sind heterotrophe Lebewesen, zu denen der Mensch, alle bekannten Tierarten, Pilze und viele Bakterien gehören. Sie nehmen regelmäßig Nahrung auf, die ihr Stoffwechsel in Baustoffe und Energie verwandelt. Stoffwechsel bedeutet, dass Rohmaterial aus der Nahrung im Verdauungssystem aufbereitet wird, bevor sie über das Blut in alle Körperzellen gelangt. Dort wird sie als Energieträger oder Baustoff verwendet. Die entstandenen Abfallprodukte werden im Anschluss entsorgt. Im Zentrum der Energiegewinnung stehen in der Zelle die Mitochondrien.
Energie und Baustoffe sind die Grundlage dafür, dass sich alle Zellen in regelmäßigen Abständen teilen und vermehren. Bei der Vermehrung der Bakterien verdoppelt sich die Bakterienanzahl immer nach einer bestimmten Zeit und heißt deswegen exponentiell. Zum Zweck der Vermehrung betreiben Zellen die sogenannte Proteinbiosynthese: Sie erstellen auf Basis ihrer Erbinformationen (DNA) Kopien, die Ribonukleinsäuren (RNA). Dieser Vorgang wird als Transkription bezeichnet. Diese mRNA-Kopien dienen als Bau- und Konstruktionspläne für die Bildung neuer Proteine. Ein Vorgang, der als Translation bezeichnet wird.
Zelldifferenzierung
Darüber hinaus können sich viele Zellen differenzieren. Unter der Zelldifferenzierung versteht man die Fähigkeit von Zellen und Geweben, sich zu einem höher spezialisierten Zustand zu entwickeln. So entwickelt sich die befruchtete Eizelle (Zygote) durch Zellteilung zu insgesamt 220 verschiedenen Zelltypen, die sich zu bestimmten Geweben verbinden. Einige Beispiele sind Haut-, Herz-, Muskel-, Nerven- oder Nierenzellen beim Menschen, die allesamt unterschiedliche Funktionen ausüben und sich auch in puncto Phänotyp unterscheiden.
Eukaryoten und Prokaryoten
Die Zellen von Pflanzen, Tieren und Menschen zählen zu den sogenannten Eukaryoten (auch Eukaryonten). Sie haben alle gemeinsam, dass sie einen Zellkern besitzen, in dem sich die Erbinformation befindet. Eukaryotische Zellen enthalten folgende Organellen und Strukturen:
- Nucleolus
- Zellkern (Nukleus)
- Ribosomen
- Vesikel
- Raues endoplasmatisches Retikulum (ER)
- Golgi-Apparat
- Mikrotubuli
- Glattes endoplasmatisches Retikulum (SER)
- Mitochondrien
- Lysosom
- Zytosol
- Peroxisom
- Zentriolen
Daneben gibt es noch die große Gruppe der Prokaryoten. Das sind Lebewesen, die keinen Zellkern haben. Bei ihnen schwimmt die DNA frei in der Zelle. Der Zelltyp der Prokaryoten wird als Protocyte bezeichnet. Alle Bakterien wie zum Beispiel das im Darm vorkommende Bakterium Escherichia coli gehören zu den Prokaryoten.
Alle Prokaryoten sind Einzeller, aber nicht alle Einzeller sind im Umkehrschluss Prokaryoten, haben also keinen Zellkern. Ausnahmen bilden zum Beispiel das Pantoffeltierchen und das Augentierchen (Euglena). Sie gehören zu den eukaryoten Einzellern, verfügen also über einen Zellkern.

Das Augentierchen gehört zu den bekanntesten geißeltragenden eukaryotischen Einzellern. Es bewegt sich über einen beweglichen Schweif die sogenannte Geißel fort und hat einen Pigmentfleck, der es ihm ermöglicht, Lichtreize aufzunehmen. Eine weitere Besonderheit ist die Tatsache, dass Augentierchen wie Pflanzen Fotosynthese betreiben.
Alle Videos und Lerntexte zum Thema
Videos und Lerntexte zum Thema
Tier- und Pflanzenzellen (Eukaryoten) (12 Videos, 1 Lerntext)
Alle Arbeitsblätter zum Thema
Arbeitsblätter zum Thema
Tier- und Pflanzenzellen (Eukaryoten) (10 Arbeitsblätter)
-
 Zellen (Basiswissen)
PDF anzeigen
Zellen (Basiswissen)
PDF anzeigen -
 Zellen – die Grundbausteine aller Lebewesen
PDF anzeigen
Zellen – die Grundbausteine aller Lebewesen
PDF anzeigen -
 Aufbau von tierischen und pflanzlichen Zellen
PDF anzeigen
Aufbau von tierischen und pflanzlichen Zellen
PDF anzeigen -
 Organisationsstufen – Zellen, Gewebe, Organe
PDF anzeigen
Organisationsstufen – Zellen, Gewebe, Organe
PDF anzeigen -
 Pflanzenzelle – Aufbau und Struktur
PDF anzeigen
Pflanzenzelle – Aufbau und Struktur
PDF anzeigen -
 Tierzelle – Aufbau und Struktur
PDF anzeigen
Tierzelle – Aufbau und Struktur
PDF anzeigen -
 Die Zellteilung
PDF anzeigen
Die Zellteilung
PDF anzeigen -
 Zelldifferenzierung – Organisationsebenen von Tier- und Pflanzenzellen
PDF anzeigen
Zelldifferenzierung – Organisationsebenen von Tier- und Pflanzenzellen
PDF anzeigen -
 Zellatmung – lebensnotwendig für alle Zellen
PDF anzeigen
Zellatmung – lebensnotwendig für alle Zellen
PDF anzeigen -
 Stoffwechsel – Energiegewinnung in Tier- und Pflanzenzellen
PDF anzeigen
Stoffwechsel – Energiegewinnung in Tier- und Pflanzenzellen
PDF anzeigen
Beliebteste Themen in Biologie
- Was ist DNA
- Organe Mensch
- Meiose
- Pflanzenzelle
- Blüte Aufbau
- Feldmaus
- Chloroplasten
- Chlorophyll
- Rna
- Chromosomen
- Rudimentäre Organe
- Wirbeltiere Merkmale
- Mitose
- Seehund
- Modifikation
- Bäume Bestimmen
- Metamorphose
- Synapse
- Synapse Aufbau und Funktion
- Ökosystem
- Amöbe
- Blobfisch
- Phänotyp
- Endoplasmatisches Retikulum
- Karyogramm
- RGT Regel
- Biotop
- Eukaryoten
- Zellmembran
- Calvin-Zyklus
- Codesonne
- Fotosynthese
- Allel
- Ribosomen
- Golgi-Apparat
- Nukleotid
- Mitochondrien
- Genotyp
- Zellorganellen
- Phospholipide
- Vakuole
- Gliazellen
- Nahrungskette Und Nahrungsnetz
- Phagozytose
- Vesikel
- Biozönose
- tRNA
- Kompartimentierung
- Sympatrische Artbildung
- Transpiration














